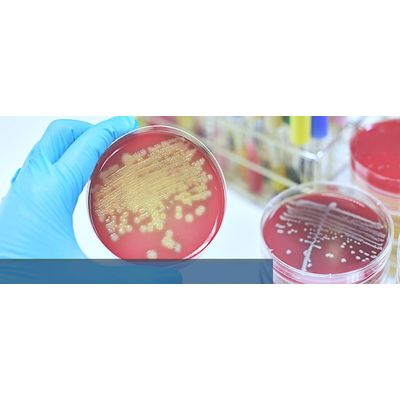
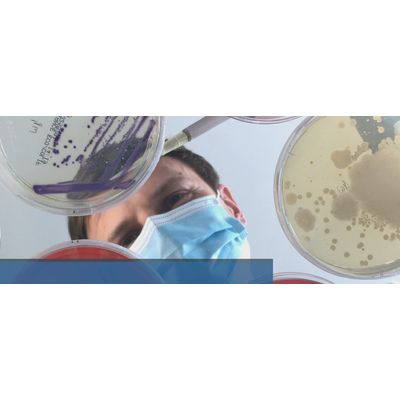

INTER-ARRAY by fzmb GmbH
3 products found
INTER-ARRAY by fzmb GmbH products
Model S. aureus - Genotyping Kit
The microarray hybridization kit enables the DNA-based detection of antibiotic resistance genes, virulence genes and pathogenicity markers of Staphylococcus aureus. This enables simple and quick assignment of unknown Staphylococcus aureus isolates to known strains. A result from an overnight bacterial culture can be obtained within hours.
Reagents for Genotyping
In addition to the kits for genotyping specific bacteria, INTER-ARRAY also offers the reagents for the individual process steps for universally applicable assays. These reagents can be used for cell lysis and DNA extraction, biotin labelling of extracted DNA, hybridization and amplification, detection and staining of microarrays. These reagents are offered individually or as kits (e. g. Lysis Kit, Labelling and Hybridization Kit, Hybridization Kit) and can also be combined with custom microarray strips immobilized with probes in spotting technique if required.
Further Genotyping Kits
INTER-ARRAY genotyping with microarrays is robust, inexpensive and fast, differentiates between identical and clonally related strains and captures the core genome and varying genes. The combination of rapid genome sequencing of selected isolates with high-throughput bacterial typing allows many questions from the areas of hygiene monitoring, outbreak management, infection research and epidemiology to be answered.